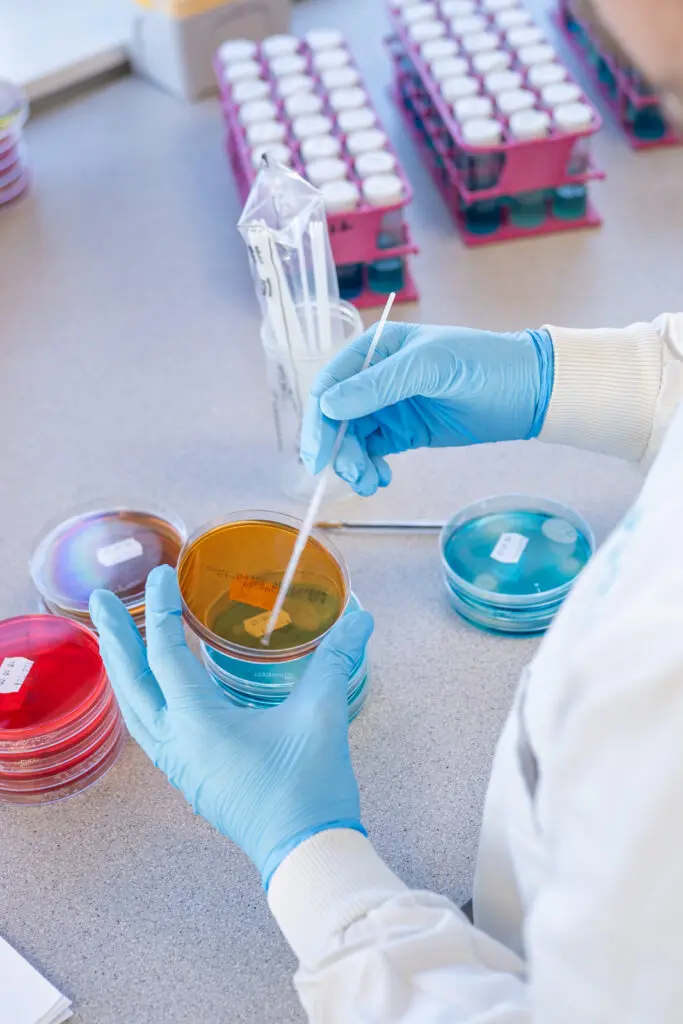
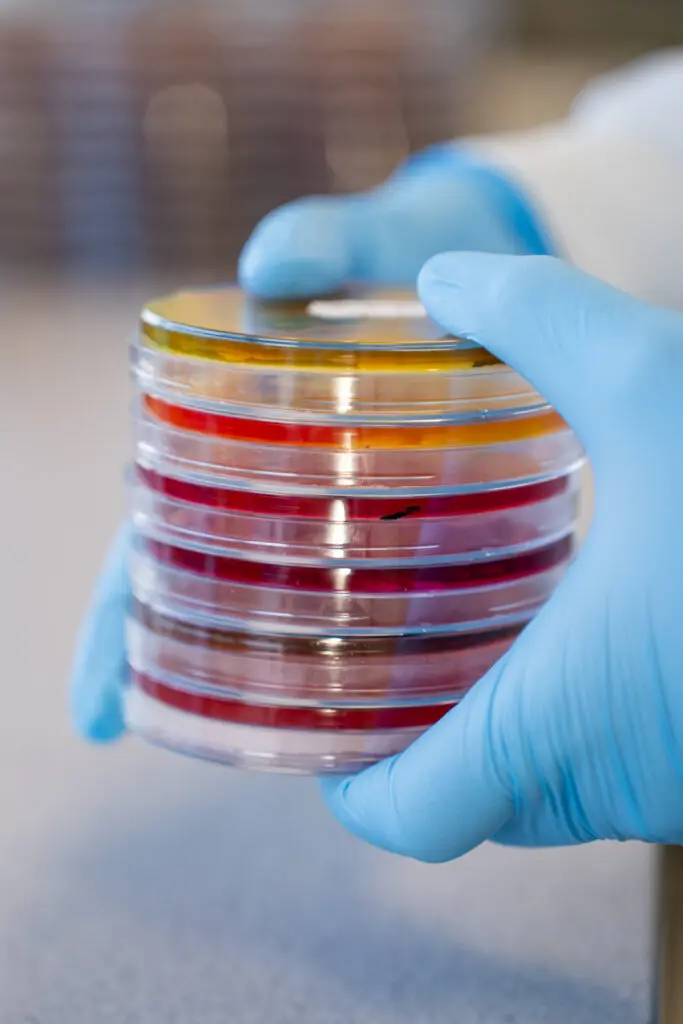

Faecal Egg Count Testing in Poultry: A Practical Tool with Important Caveats
By Alistair Chilcott BVetMed MRCVS
Faecal egg count (FEC) testing is increasingly used in poultry production as a non-invasive way to assess intestinal parasite burdens. In laying hens, broilers and turkeys, FECs can provide valuable insight into the presence and relative pressure of both intestinal worms (nematodes) and coccidial infection, supporting evidence-based health management decisions.
For worms, FEC testing measures the number of parasite eggs shed in droppings, usually reported as eggs per gram (EPG). The most common nematodes encountered in poultry include Ascaridia galli, Heterakis gallinarum and Capillaria species. While FECs are useful for identifying exposure and monitoring trends over time, it is important to understand that egg counts do not directly equate to worm numbers.
Different worm species have markedly different egg-laying capacities. Ascaridia galli, the large roundworm of the small intestine, is extremely prolific, with a single mature female capable of shedding tens of thousands of eggs per day. In contrast, Heterakis gallinarum and Capillaria species produce far fewer eggs. As a result, even a relatively small number of A. galli worms can dominate the egg count in mixed infections, potentially masking the presence of other species. Because A. galli and H. gallinarum eggs are difficult to distinguish microscopically, they are usually reported together, adding another layer of interpretation.
Sampling itself also matters. Heterakis gallinarum lives in the caeca, and its eggs are mainly shed in the distinctive caecal droppings passed only once or twice a day. Random faecal samples that consist largely of standard intestinal droppings may therefore underestimate—or even miss—Heterakis infections, particularly if sampling is limited.
For these reasons, FEC results should be viewed as an indicator of parasite pressure, rather than a precise measure of worm burden. Repeated testing over time, consistent sampling methods, and interpretation alongside bird age, performance data, treatment history and clinical signs are key to making the results meaningful.
Faecal testing can also be used to assess coccidial burden by counting oocysts per gram (OPG). As with worm eggs, oocyst counts vary with species, stage of infection and immunity. In well-managed flocks, low-level oocyst cycling may be normal and even beneficial for immunity, whereas rising counts combined with performance losses may signal emerging disease or breakdown in control.
In summary, faecal egg count testing is a valuable, practical monitoring tool for poultry producers. When used thoughtfully—and with an understanding of its limitations—it can support targeted interventions, reduce unnecessary treatments and contribute to more sustainable parasite control programmes across layers, broilers and turkeys.
Top tips for faecal sampling in poultry
- Sample fresh droppings only Collect droppings that are still moist and recently passed. Old or dried samples can underestimate egg or oocyst counts due to degradation.
- Take multiple samples Parasite egg shedding is uneven. Pooling droppings from at least 10–20 locations within a shed gives a more representative picture than relying on one or two samples.
- Include caecal droppings where possible The dark, pasty caecal droppings are especially important for detecting Heterakisgallinarum, as its eggs are shed mainly via the caeca and may be missed in standard intestinal droppings.
- Be consistent over time Use the same sampling method, number of droppings and timing each time you test. This makes trends over time far more meaningful than single “snapshot” results.
- Consider bird age and system Young birds, free-range flocks and multi-age systems may show different egg or oocyst patterns. Interpret results in the context of age, housing, range access, performance data and treatment history.
Live salmonella vaccine licensed for use in lay in the UK
Following approval by BEIC, further details regarding its practical use and any associated training requirements will be communicated in due course.
The vaccine claims are as follows:
Prolonged Salmonella control up to 100 weeks of age: 4th dose around the 50th week of life, providing a total duration of immunity of around 100 weeks for Salmonella Enteritidis and around 94 weeks for Salmonella Typhimurium*.
Zero-day egg withdrawal: no loss of production after *
Powerful Salmonella protection: the only live dual strain vaccine containing both Salmonella Enteritidis and Typhimurium.
This represents a significant development in Salmonella control options for laying flocks in the UK. If you have any queries regarding this vaccine, please contact your local PHS branch to discuss with your vet.
Tom Dutton will deliver a presentation together with Sara Perez (PHS Clinical Director) on the 15th April 2026, at the Yorkshire Egg Producers Discussion Group. The topics will be vaccination for salmonella in lay and Avian Flu vaccination. If you wish to attend or would like more information about the meeting, please contact
Josh Dent : [email protected]

From Sample to Results: What happens in the Lab?
By Samantha Searle BSc (Hons) MSc

Have you ever wondered what happens to your Salmonella samples once they arrive at the laboratory and why it can take 5 days for a result? Understanding the process can help you see how your
results are generated.
Day 1 Sample Logging and Set Up
When the samples arrive, they are checked for condition and given a unique reference number before logging them. Proper labelling of the samples at the farm and prompt delivery help ensure a smooth process at this stage. The samples are then set up in a pre-enrichment media for 18 hours to help any Salmonella that might be present to grow and multiply.
Day 2 Selective Enrichment
The samples are then plated onto a selective media to allow for preferential growth of Salmonella over competing bacteria. This plate is incubated for 24 or 48 hours depending on growth which is the reason we state 4 to 5 days of testing as this stage is unpredictable.
Day 3/4 Selective Plating
The samples are then streaked onto two different agar plates and incubated for a further 24 hours. These plates isolate the Salmonella colonies if present.
Day 4/5 Reading the Results
If your sample is negative the results will be reported and uploaded to you. However, suspect isolates undergo further confirmation testing before results are reported after another 24 hours of incubation.
Day 5/6 Confirmation
The isolated colonies will be confirmed, and we will report the type of Salmonella that has been detected.
Upcoming Events

British Pig & Poultry Fair will NEC, Birmingham on Wednesday 13th and Thursday 14th May 2026
Come and meet the PHS team at the event on stand 6-460. See you there!!
Free entry – click here to register your interest for the 2026 Fair
